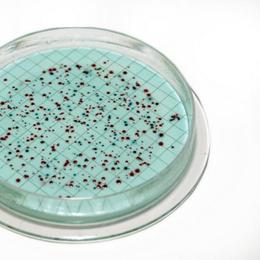

- milvit.cz
- Píšeme pro Vás
- Kvalita vody, původ vody a chemický rozbor vody
Kvalita vody, původ vody a chemický rozbor vody

Kvalita vody se obvykle pouhým okem nepozná. Je závislá především na podloží v místě vodního zdroje. Kromě veřejných vodovodů jsou studny nejčastějším zdrojem vody pro domácnosti.
Kopané studny
Jsou obvykle starší a bývá v nich spíše povrchová voda s vyšší tvrdostí a obsahem dusičnanů. Výjimečně pak zde jsou koliformní bakterie, svědčících o blízkosti netěsné žumpy nebo jiného zdroje znečištění.
Vrtané studny
Jsou nejčastější typ nových vodních zdrojů, obsahujících převážně spodní vodu a v naprosté většině případů majících zvýšený obsah železa a manganu. Voda z vrtaných studen proto občas mírně zapáchá. Dusičnany se ve vodě z vrtů takřka nevyskytují.
Nejčastějším dokladem kvality vody je její chemický rozbor. Zde je komentář k nejčastěji sledovaným ukazatelům:
Tvrdost vody
Jedním z ukazatelů, které obvykle charakterizují kvalitu vody, je tzv. „tvrdost vody“. Přestože se jedná o nejednoznačný termín, jehož význam není zcela přesně definován a moderní hydrochemie se mu snaží vyhýbat, je mezi laickou veřejností i v řadě odvětví stále hojně využíván.
Vápník
Vápník představuje hlavní složku tvrdosti vody a je ze zdravotního hlediska prospěšný. Napomáhá ke zdravému růstu a zabraňuje odvápnění organizmu. Je tedy doporučeno konzumovat spíše vodu tvrdší, ačkoli by tvrdost neměla dlouhodobě přesahovat určité hranice. Striktní hodnoty tvrdosti vody, jež by bylo nutné dodržovat, legislativa neupravuje. Ve vyhlášce pro pitnou vodu je však stanoveno doporučené rozmezí 2,0-3,5 mmol/l. Tyto hodnoty odpovídají obvyklému složení vody z vodovodu v českých domácnostech, která tak představuje nejpřístupnější zdroj vápníku pro lidský organismus.
Hořčík
Zdraví prospěšný v určitém množství je také hořčík. Oba tyto prvky jsou žádoucí jako prevence úmrtí na srdečně-cévní onemocnění a zřejmě i jako prevence některých jiných chorob. V koncentracích nad 100 mg/l může mít hořčík v přítomnosti síranů projímavý účinek. Hořčík a vápník jsou přirozená součást vod, jejich obsah se však někdy mírně zvyšuje při stabilizaci vody pomocí vápna, vápence či dolomitu.
Barvitost a zápach vody
Naopak co určitě nikdo rád nevidí je, pokud má voda hnědo-červené zabarvení. Jedovatá sice není, ale určitě snižuje spotřebitelskou kvalitu. Zabarvení vzniká přítomností přirozených organických látek typu huminových látek a fulvokyselin nebo přítomností kovů, zejména železa, ať už přírodního původu, nebo z koroze potrubí. Jak již bylo dříve zmíněno, odstranění železa a manganu je nejčastěji požadováno u vrtaných studní.
Další nevítanou přísadou jsou amonné ionty, které působí jako ne zcela spolehlivý indikátor fekálního znečištění. Projevují se zápachem vody po shnilých vejcích. V koncentracích ve vodě obvyklých jsou prakticky netoxické, ale mohou snížit účinnost dezinfekce, vést k tvorbě dusitanů v potrubí, nebo být příčinou pachových a chuťových problémů ve vodě. Mohou též zapříčinit selhání filtrů k odstraňování manganu. Vzácně mohou být přírodního geologického původu, ale nejobvyklejším zdrojem znečištění jsou odpadní vody z měst nebo z živočišné výroby, protože amonné ionty jsou produktem rozkladu dusíkatých organických látek. Dále se mohou do pitné vody dostat při dezinfekci chloraminem a z nové cementové výstelky potrubí.
Dusičnany a dusitany ve vodě
Co by se mělo ve složení pitné vody objevit v limitovaném množství, jsou dusičnany a dusitany. V lidské krvi reagují s hemoglobinem za vzniku methemoglobinu a způsobují riziko vnitřního dušení, hlavně u kojenců do tří měsíců věku. V zažívacím traktu se dusičnany mohou redukovat na dusitany, které reagují se sekundárními aminy v potravě za vzniku takzvaných N-nitroso sloučenin, které jsou podezřívány z karcinogenního účinku. Proto je odstraňení dusičnanů z vody velice žádoucí. Tyto látky mají nepříznivý vliv také na reprodukční funkce. Do vody se dostávají z lidských a zvířecích výkalů nebo z odpadních vod vyprodukovaných ve městech a vesnicích. Možné jsou také splachy ze zemědělské půdy nebo kontaminace umělými hnojivy
Desinfekce vody
Chlór se do pitné vody přidává jako nejběžnější desinfekční prostředek. V povolené koncentraci (do 0,3 mg/l) je chlór přítomný ve vodě zdraví neškodný, ovšem citlivější osoby i tuto koncentraci mohou vnímat jako nepříjemný pach i chuť pitné vody. U citlivých osob může výjimečně dojít také k podráždění pokožky. Chlorace vody je kromě drahé ionizace a použití UV-lamp jednou z možností desinfekce vody.
Klíčová slova: kvalita vody, původ vody, rozbor vody, desinfekce vody, dusitany a dusičnany, tvrdost vody, vápník, hořčík, dusičnany ve vodě, odstranění dusičnanů z vody, dusičnany, dusitany ve vodě
Jestliže máte problém s kvalitou Vaší vody, zašlete její vzorek na výše uvedenou adresu s popisem problému. Pokud disponujete rozborem vody, zašlete nám jej na náš email info@milvit.cz
Zdarma Vám vyhotovíme nabídku filtrační technologie na míru, kterou budeme garantovat požadovanou výslednou kvalitu Vaší vody pro domácnosti i průmysl.

+420 720 976 036
Po‐Pá 7:30‐15:00


Proč nakupit u nás